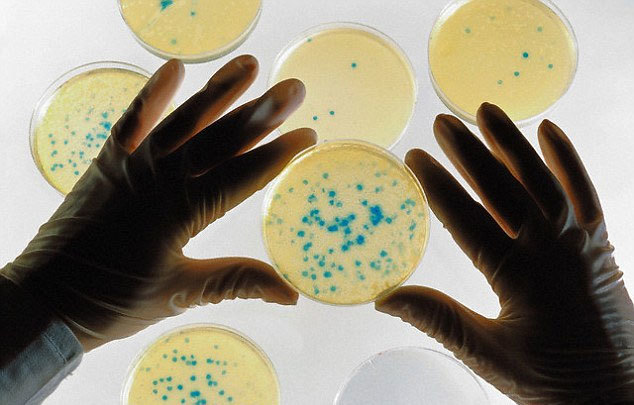
{keywords}

Các sinh vật biến đổi gen (GMO) có thể giúp cải thiện cuộc sống của con
người, nhưng chúng cũng tiềm ẩn khả năng biến thành những mầm bệnh quái ác. Để
kiểm soát nguy cơ này, các nhà khoa học đang tạo ra "công tắc hủy diệt", đóng
vai trò như bộ phận ngắt khẩn cấp đối với GMO.
Các cơ chế được thiết kế đặc biệt sẽ không chỉ hủy diệt sinh vật biến đổi gen nếu chúng thoát ra khỏi phòng thí nghiệm, mà còn xóa bỏ bất kỳ dấu vết nào về thông tin di truyền từng được dùng để tạo ra chúng. Những "công tắc hủy diệt " này đang được các nhà khoa học đến từ Viện Công nghệ Massachusetts (MIT) và Đại học Harvard ở Mỹ phối hợp nghiên cứu phát triển.
"Bạn chỉ cần cắm nối vào phần muốn xóa bỏ trong sinh vật biến đổi gen và khi hệ thống được bật lên, nó sẽ xóa bỏ ADN mục tiêu và hầu như không làm suy chuyển ADN khác", nhà nghiên cứu Christopher Voigt thuộc MIT giải thích.
Giải pháp này được mô tả tương tự như giải pháp trụ neo (thanh ghi), vốn dựa vào các mô hình tàu hỏa. Cũng giống như với một đoàn tàu, người lái tàu cần phải đặt tay lên cần gạt hoặc công tắc thanh ghi. Nếu người lái tàu bị mất kiểm soát, tay họ sẽ buông lỏng và các phanh của tàu sẽ phát huy tác dụng.
Trong trường hợp của "công tắc hủy diệt" đối với các hệ gen, một hóa chất nhất định luôn phải có mặt hoặc công tắc sẽ kích hoạt và sinh vật sẽ chết. Một loại công tắc hủy diệt vi trùng khác là Passcode, đòi hỏi sự kết hợp của 3 phân tử nhỏ, chẳng hạn như các phân tử A và B, nhưng thiếu vắng hoàn toàn phân tử C. Các nhà thiết kế cũng có thể chọn bất kỳ chuỗi hoặc "passcode" nào mà họ muốn.
Hồi đầu năm nay, các chuyên gia đến từ Đại học Havard và Đại học Yale (Mỹ) từng công bố dữ liệu của một nghiên cứu, trong đó họ đã biến đổi ADN của vi khuẩn E. coli để chúng không thể sống sót nếu thiếu một số amino axit (các khối xây dựng protein) nhất định. Những amino axit này không tồn tại trong tự nhiên, mà chỉ được tìm thấy trong phòng thí nghiệm. Do đó, nếu sinh vật biến đổi gen như vi khuẩn E. coli biến đổi ADN nói trên thoát ra khỏi sự kiểm soát của con người, chúng sẽ chết.
Thành công trên đã cắt giảm rủi ro vô tình phóng thích sinh vật biến đổi gen cũng như nguy cơ vốn có của việc sản sinh cũng như thử nghiệm với các vi sinh vật tự tái tạo. Do Passcode hiệu quả đối với vi khuẩn E.coli, nên các nhà nghiên cứu kỳ vọng nó cũng sẽ hiệu quả với các loại vi khuẩn khác.
Tuấn Anh (Theo Daily Mail)